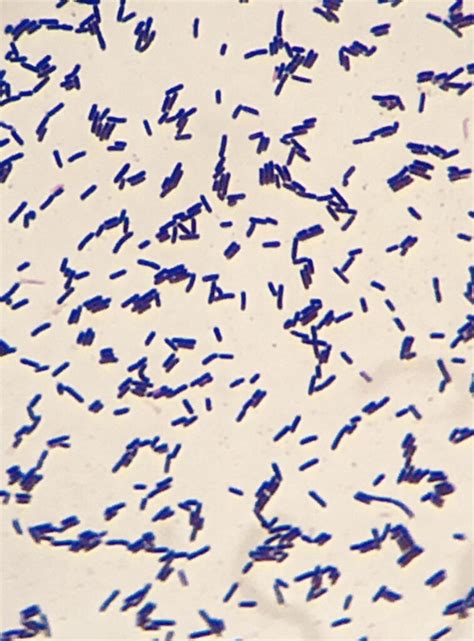
Microscopio che mostra batteri lattici

Con il termine fermenti lattici si è soliti indicare selezionati ceppi batterici coinvolti nella fermentazione del latte e in grado di metabolizzare il lattosio. Il termine "fermento lattico" è stato tradizionalmente usato per identificare i batteri produttori di acido lattico partendo dalla fermentazione del lattosio, il principale zucchero presente nel latte. Si tratta quindi di microrganismi che sono in grado di fermentare e di “digerire” il lattosio. Il loro utilizzo è noto fin dall’antichità, in quanto venivano utilizzati per preservare il latte e fare buoni alimenti come lo yogurt e i formaggi. Con “fermenti lattici” si intendono tutti quei batteri “buoni” che usano come fonte energetica primaria il lattosio e lo trasformano in acido lattico, che viene liberato come “prodotto di scarto” del loro metabolismo. L’acido lattico viene prodotto dai batteri lattici attraverso un processo di fermentazione, chiamato appunto “fermentazione lattica“, del tutto analogo a quello che avviene nelle cellule dei muscoli quando si svolge attività fisica anaerobica.
I fermenti lattici sono solo una parte dei microrganismi che risiedono nell’intestino umano e compongono il microbiota intestinale. Alcuni batteri lattici fanno infatti parte del più ampio gruppo dei probiotici, ovvero microrganismi in grado di arrivare vivi e vitali nell’intestino e di favorire l’equilibrio della flora (o microbiota) intestinale, garantendo così la salute e il benessere intestinale.
La Differenza tra Fermenti Lattici e Probiotici
C'è spesso molta confusione tra i termini fermenti lattici e probiotici, che sono spesso usati come sinonimi. In realtà non lo sono e la differenza è enorme. Anche se i fermenti lattici rientrano nella categoria dei probiotici, non è vero il contrario. Secondo l’Organizzazione Mondiale della Sanità i probiotici sono organismi viventi che, se somministrati in quantità sufficienti, possono conferire uno stato di salute all'organismo ospite. Sono microrganismi che producono acido lattico nella maggior parte dei casi. A differenza dei fermenti lattici, però, rimangono vitali nell'organismo, dove si replicano e svolgono attività metaboliche che apportano benefici. Inoltre, mentre i probiotici sono in grado di riequilibrare la flora batterica intestinale, i fermenti lattici non sortiscono alcun effetto su questi batteri buoni. I fermenti lattici probiotici, tutti derivati dall'uomo e altamente resistenti agli effetti della digestione, se assunti per via orale e a stomaco vuoto, hanno la capacità di raggiungere intatto l'intestino. Qui possono moltiplicarsi, migliorandone la salute del nostro intestino e di tutto l’organismo. Possono anche essere ingeriti attraverso alimenti, come yogurt, kefir, latticello, alcuni formaggi a pasta molle, crauti, cetrioli fermentati. In questo caso la maggior parte di loro viene eliminata dalla barriera gastrica caratterizzata da un pH molto acido, dovuto alla presenza di acido cloridrico.
Tuttavia, nella maggioranza delle credenze comuni tra fermenti lattici e probiotici non esiste alcuna differenza, infatti si pensa spesso (erroneamente) che si tratti pur sempre della stessa cosa. In realtà, i probiotici sono particolari tipi di batteri o lieviti fisiologici (cioè presenti in natura all’interno dell’intestino) che vengono selezionati e riprodotti in colture. Sono quelli che comunemente troviamo negli integratori, o in alcuni alimenti rinforzati, e sono definiti dalla FAO e dall’OMS come dei microrganismi vivi e vitali che, se consumati in adeguate quantità (più di almeno 10⁹ UFC al giorno*) sono in grado di superare indenni la barriera acida dello stomaco e arrivare vivi nell’intestino. Generalmente si pensa che i probiotici possano arricchire, anche se temporaneamente, la flora batterica intestinale conferendo un effetto benefico alla salute dell’ospite, ma ad oggi non ci sono studi clinici che dimostrino effetti certi sulle disbiosi intestinali.
Qual è, in sintesi, la differenza tra probiotici e fermenti lattici? I primi rimangono vivi all’interno dell’organismo mentre i secondi, una volta ingeriti, in genere non sopravvivono al passaggio dallo stomaco all’intestino, a prescindere dal fatto che possano svolgere o meno un’azione benefica sulla nostra salute. * UFC: "unità formanti colonie", unità di misura dei batteri. Siccome i batteri sono molto numerosi, per contarli si usano le potenze del 10. In questo caso, 10⁹ corrisponde a un miliardo: secondo la definizione FAO e OMS, solo se i batteri sono presenti nell’alimento/integratore in questa quantità minima sono in grado di arrivare fino all'intestino e colonizzarlo. Se, ad esempio, ci trovassimo di fronte ad un integratore/alimento che contiene un milione di batteri (quindi 10⁶), sappiamo già che ne contiene un quantitativo che non è sufficiente per arrivare fino all’intestino e integrarsi.
La differenza tra fermenti lattici e probiotici è spesso fonte di confusione anche se in Italia, dal punto di vista normativo, si tratta principalmente di una questione terminologica legata alla quantità e alla caratterizzazione dei ceppi batterici presenti nel prodotto. Il termine “fermenti lattici” è spesso usato nel linguaggio comune, ma non ha una definizione normativa precisa; il termine “probiotico” è invece regolamentato: può essere usato solo se il prodotto contiene ceppi batterici vivi, identificati e in quantità adeguata (≥10⁹ cellule vive), come indicato in specifiche Linee guida del Ministero della Salute. Quindi probiotici e fermenti lattici sono la stessa cosa? Per rispondere a questa domanda possiamo dire che un prodotto con fermenti lattici può essere definito “probiotico” solo se rispetta questi requisiti, altrimenti rimane un generico “fermento lattico”.
A Cosa Servono i Fermenti Lattici e Probiotici
Ai fermenti lattici viene attribuito un potenziale effetto di protezione per l’organismo umano, grazie alla loro attività protettiva sulla flora batterica intestinale (da cui derivano poi una serie di conseguenze positive per la salute di tutto l'organismo). Poiché sono in grado di resistere all’azione del succo gastrico e della secrezione biliare, i fermenti lattici riescono a insediarsi nell’intestino: aderendo alle cellule epiteliali, impediscono la proliferazione di ceppi batterici patogeni, dando vita a una flora batterica intestinale più sana ed equilibrata. La flora batterica intestinale così "fortificata", secondo diversi studi, avrebbe ricadute benefiche per tutto l'organismo, grazie alle possibili conseguenze positive sul sistema immunitario.
I fermenti lattici sarebbero inoltre in grado di riequilibrare la flora batterica intestinale in caso di squilibrio, come accade per esempio, quando si assumono farmaci antibiotici. I fermenti lattici spesso vengono inoltre consigliati in accompagnamento alle terapie per il trattamento di diverse disfunzioni dell'apparato digerente. Infine, alcuni studi hanno messo in evidenza come l'azione dei fermenti lattici sull'intestino risulti benefica anche in caso di altre patologie, come sindromi infiammatorie intestinali e allergie alimentari, ma anche in caso di infezioni dell'apparato respiratorio e urinario.
I probiotici sostengono il benessere intestinale. Infatti, supportano l’organismo nel processo di equilibrio della flora batterica, anche in caso di alterazioni, dovute ad esempio a stress o terapie farmacologiche. I probiotici, ad esempio, più che essere rimedi contro la diarrea, possono risultare utili per aiutare il corpo nel prevenirla.
Un importante fattore che può indurre disbiosi è un’alimentazione sbilanciata, troppo ricca di grassi, proteine e calorie e povera di carboidrati complessi e fibre vegetali, come quella caratteristica dei Paesi occidentali. I fermenti lattici possono essere presi in considerazione anche tra le soluzioni naturali contro l’intestino pigro e la stipsi cronica. Cicli di assunzione di fermenti lattici possono essere utili anche per alleviare i sintomi della sindrome dell’intestino irritabile (IBS), una condizione molto diffusa sia tra gli adulti sia tra i bambini e aggravata da dieta poco sana e stress.

Probiotici, Prebiotici e Simbiotici
Come abbiamo appena visto, il termine probiotico indica tutti quei microrganismi che, se assunti in adeguate quantità, possono svolgere un’azione benefica per l’organismo. Quindi gli alimenti/integratori con probiotici sono alimenti che contengono, in numero sufficientemente elevato, microrganismi probiotici vivi e attivi in grado di raggiungere l’intestino, moltiplicarsi e svolgere una funzione di equilibrio sulla microflora intestinale tramite una colonizzazione diretta. Il termine prebiotico, invece, si riferisce alle sostanze non digeribili di origine alimentare che, se introdotte nelle giuste dosi, favoriscono la crescita e l’attività di uno o più batteri già presenti nel tratto intestinale (spesso usate insieme ai probiotici). Pertanto, gli alimenti/integratori con prebiotici sono alimenti che contengono in quantità adeguata molecole prebiotiche in grado di promuovere lo sviluppo di gruppi batterici utili al nostro organismo. Inoltre, è possibile assumere i probiotici insieme ai prebiotici, ossia sostanze alimentari non digeribili che, assunti in quantità adeguate, favoriscono la attività dei batteri nel tratto intestinale. Infatti, i prodotti che presentano allo stesso tempo probiotici e prebiotici vengono definiti simbiotici.
Quando e Come Assumere Fermenti Lattici e Probiotici
Per essere efficaci i probiotici dovrebbero essere assunti sempre e solo a stomaco vuoto, per un tempo medio di 3-4 settimane e in un quantitativo di almeno un miliardo di batteri al giorno (10⁹ UFC). Generalmente, può essere consigliato assumere probiotici, ad esempio, dopo una terapia antibiotica, così da aiutare l’organismo nel naturale riequilibrio del microbiota. Per individuare il momento migliore della giornata per l’integrazione, è sempre bene seguire le indicazioni riportate sulla confezione del prodotto acquistato. Tuttavia, tendenzialmente, sarebbe preferibile prendere i probiotici lontano dai pasti e non superare la dose giornaliera raccomandata del prodotto. Attenzione però: ricorda che l’integrazione non sostituisce uno stile di vita sano e una dieta equilibrata. Inoltre, si suggerisce un consulto con il proprio medico alle persone con gravi immunodeficienze o con malattie croniche.
Se sono presenti disturbi intestinali specifici che prevedono anche terapie farmacologiche o in caso di diarrea indotta da antibiotici, il consiglio è seguire le indicazioni del medico in merito alla tipologia di fermenti lattici da usare, alla modalità e ai tempi del trattamento. La durata del trattamento varia da caso a caso, ma di norma 1-2 settimane di assunzione di integratori alimentari probiotici sono sufficienti per ottenere il riequilibrio della flora batterica intestinale.
I fermenti lattici devono essere assunti preferibilmente prima dei pasti, a stomaco vuoto. Dopo quanto tempo i fermenti lattici fanno effetto? L’effetto dei fermenti lattici è graduale ed individuale. Come assumerli: per via orale. In capsule o bustine. A base di probiotici e fermenti lattici vivi.
Probiotici e Prebiotici: cosa sono e come aiutano il tuo intestino
Alimenti Ricchi di Fermenti Lattici e Probiotici
Come detto, la dieta varia ed equilibrata è sempre la scelta più giusta per una vita sana. Infatti, già attraverso l’alimentazione è possibile assumere fermenti lattici e probiotici in quantità utile all’organismo. Dunque, per favorire il mantenimento della flora intestinale si possono includere nella propria dieta alimenti con probiotici.
Questi batteri sono presenti anche in diversi alimenti fermentati, come yogurt, kefir, latticello, alcuni formaggi freschi, verdure fermentate (es. crauti) e sottaceti.
Come già detto precedentemente, lo yogurt non contiene probiotici. I suoi batteri (Streptococcus thermophilus e Lactobacillus bulgaricus) non resistono all’azione dei succhi gastrici e muoiono prima di arrivare nell’intestino. Questo non significa, però, che dobbiamo escludere lo yogurt dalla nostra alimentazione, anzi. Latte e derivati, come il formaggio Grana Padano DOP, sono alimenti indispensabili per la salute del nostro organismo perché ci forniscono elementi essenziali per lo sviluppo dello scheletro e dei muscoli (e non solo) quali calcio, proteine ad alto valore biologico, minerali e vitamine con potere antiossidante. In particolare, in soli 25g di Grana Padano DOP possiamo trovare ben 8,25g di proteine nobili (alto valore biologico), 291mg di calcio, 90mg di vitamina B2, 0,75mg di vitamina B12, 56mg di vitamina A, 2,75 mg di zinco e 3mg di selenio.

Prodotti Specifici
Enterogermina 4 miliardi è un probiotico indicato per riequilibrare la flora intestinale alterata da antibiotici, disturbi intestinali, cambi di alimentazione o stress. Grazie ai suoi spore di Bacillus clausii, favorisce il naturale benessere dell’intestino, aiutando a ripristinare la flora batterica e migliorare le difese naturali dell’organismo.
Integratore di fermenti lattici vivi Lactobacillus rhamnosus GG utile per favorire l’equilibrio della flora intestinale, soprattutto in caso di diarrea o terapie antibiotiche. Ripristina l’equilibrio intestinale in modo sicuro ed efficace.
Codex 250 mg compresse è un medicinale a base di fermenti lattici vivi (Saccharomyces boulardii) indicato per la prevenzione e il trattamento delle diarree di origine infettiva, batterica o antibiotico-indotta.
Noi di Farmaè abbiamo selezionato per te i farmaci con fermenti lattici e probiotici migliori per la salute del tuo intestino, tra cui Enterogermina, Codex e Bioflorin. Sono disponibili sul nostro e-shop in diverse formulazioni, quali flaconi, fiale orali, polveri in bustine e capsule. Dai anche un’occhiata alla sezione del nostro shop online dedicata agli integratori con fermenti lattici.